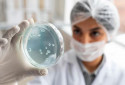
O congelamento de óvulos é uma das estratégias mais importantes para preservar a fertilidade de mulheres - Freepik
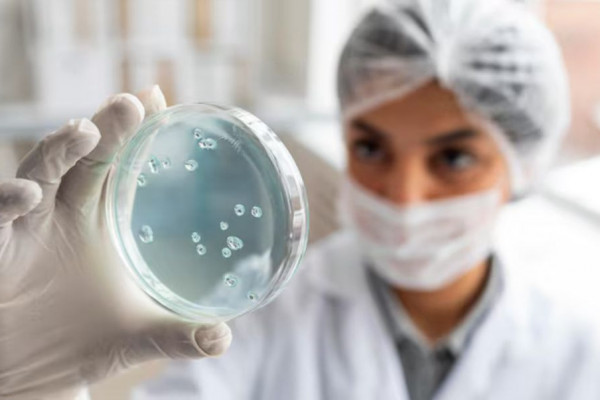
O congelamento de óvulos é uma das estratégias mais importantes para preservar a fertilidade de mulheres

Food noise: por que você só pensa em comer o dia todo?
O food noise não nasce do estômago, mas do cérebro ao tentar aliviar algum tipo de tensão interna
Publicado: 25/11/2025 às 15:30

Food noise é um termo usado para descrever o barulho mental constante sobre comida (Freepik )
Food noise é um termo usado para descrever o barulho mental constante sobre comida, mesmo quando não existe fome real. É quando a mente pensa em comer o tempo inteiro, cria vontade de beliscar sem motivo, busca alimentos logo após uma refeição ou mantém uma preocupação contínua com o que comer em seguida. O food noise não nasce do estômago, mas do cérebro ao tentar aliviar algum tipo de tensão interna.
Pensar em comida o dia todo geralmente não tem relação com necessidade fisiológica, mas com desregulação emocional, cansaço e sobrecarga. Quando a rotina está pesada, o cérebro busca um atalho para produzir alívio imediato. Assim, a comida vira um dos caminhos mais rápidos. Por isso, o food noise aparece em momentos de estresse, ansiedade, fadiga e exigência mental contínua.
A falta de sono também intensifica o problema. Noites mal dormidas aumentam os hormônios da fome e reduzem a sensação de saciedade, fazendo o cérebro insistir em pensamentos de comida mesmo após refeições suficientes. Dietas muito restritivas são outro fator importante, ou seja, quanto mais alimentos são proibidos, mais o cérebro se fixa neles, interpretando a restrição como ameaça.
O food noise é um sinal, não uma falha. Indica que algo essencial não está sendo cuidado, como descanso, organização da rotina, alimentação regular, limites e pausas. É a mente pedindo equilíbrio antes que o corpo manifeste sintomas mais claros.
Reduzir o food noise exige ajustes simples: dormir melhor, evitar longos períodos sem comer, diminuir estresse, fazer pausas verdadeiras no dia e substituir restrições extremas por equilíbrio. Comer com consciência e sem culpa, ajuda a reorganizar os sinais internos.
Portanto, pensar em comida o dia todo não é falta de disciplina, mas um pedido de cuidado que começa na mente, não no prato.
Congelamento de óvulos em pacientes oncológicas
O congelamento de óvulos é uma das estratégias mais importantes para preservar a fertilidade de mulheres, que irão iniciar tratamento contra o câncer. Isso porque quimioterapia, radioterapia e algumas cirurgias podem comprometer, de forma temporária ou definitiva, a função ovariana.
Para muitas pacientes, especialmente as mais jovens, o diagnóstico de câncer vem acompanhado de um medo adicional: o de não poder engravidar no futuro. A oncologia moderna já reconhece, oficialmente, a preservação da fertilidade como parte do cuidado integral e o congelamento de óvulos é o método mais seguro e eficaz para isso.
O processo é rápido, o que é fundamental em contextos oncológicos. Depois de avaliação médica, a paciente realiza uma estimulação ovariana por cerca de 10 a 12 dias, seguida da coleta dos óvulos. Esses óvulos são então congelados por vitrificação, técnica que mantém alta taxa de sobrevivência celular. Em muitos casos, todo o procedimento pode ser iniciado e concluído antes do início da quimioterapia, sem atrasar o tratamento principal.
O congelamento é indicado principalmente para pacientes com tumores, que exigem quimioterapia de alta toxicidade gonadal, como câncer de mama, linfomas e alguns tumores ginecológicos. Ele também pode ser recomendado, quando há necessidade de remoção dos ovários ou quando a paciente apresenta risco elevado de menopausa precoce, induzida por tratamento.
Outro ponto essencial é o suporte emocional. Para muitas mulheres, preservar a fertilidade significa preservar também um projeto de vida interrompido pelo diagnóstico. Ter a opção de recorrer aos óvulos no futuro, traz segurança psicológica e sensação de continuidade.
RJ aprova liberação de spray de defesa para mulheres

A Assembleia Legislativa do Rio de Janeiro aprovou o projeto de lei que autoriza mulheres a portar sprays de extratos vegetais, conhecidos como spray de pimenta, como instrumento de autodefesa. A proposta foi apresentada pelos deputados Sarah Pôncio e Rodrigo Amorim e segue agora para sanção do governo estadual. A iniciativa surge como resposta ao aumento dos casos de violência contra a mulher e busca oferecer um meio prático e acessível de proteção imediata.
De acordo com o texto aprovado, o produto poderá ser adquirido por mulheres maiores de 18 anos, mediante identificação, e deverá obedecer a padrões técnicos de segurança para evitar uso inadequado. A proposta não substitui políticas de prevenção, mas reconhece que, na prática, muitas mulheres enfrentam riscos reais sem qualquer recurso de defesa. A intenção é ampliar possibilidades de proteção enquanto o poder público avança em medidas estruturais.
Especialistas apontam que o spray de defesa não resolve o problema da violência de gênero, mas pode funcionar como ferramenta emergencial para interromper uma agressão e permitir fuga ou pedido de ajuda. A medida reforça a necessidade de políticas integradas que envolvam segurança pública, educação, responsabilização de agressores e acolhimento eficaz das vítimas.